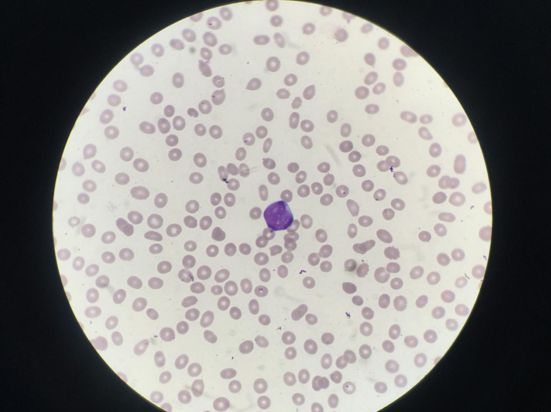

53张细胞形态,来看看认多少?

原始红细胞

早幼红细胞

中幼红细胞

晚幼红细胞

中幼红细胞胞间桥

幼红细胞分裂象

浆细胞

网状内皮细胞

嗜酸性早幼粒细胞

嗜酸性晚幼粒细胞

嗜酸性分叶核粒细胞

嗜碱性中幼粒细胞

嗜碱性晚幼粒细胞

嗜碱性分叶核粒细胞

原始粒细胞

早幼粒细胞

中性中幼粒细胞

中性晚幼粒细胞

中性杆状核粒细胞

中性粒细胞多倍体(分裂象)

颗粒性巨核细胞

产板巨核细胞

异型淋巴细胞(浆细胞型)

异型淋巴细胞(单核细胞型)

异型淋巴细胞(幼稚细胞型)
单核细胞

中性粒细胞毒性颗粒

中性粒细胞空泡变性

毛细胞

巨大血小板

中性粒细胞核小体

异型淋巴细胞核小体

退化细胞

杜勒氏小体

幼稚浆细胞

帕彭海姆氏小体

核碎裂(凋亡细胞)

NK T细胞

碎片状红细胞

中性粒细胞分叶过多(核右移)

巨多分叶核中性粒细胞

豪焦氏小体(H-J小体)

浆质体

红细胞聚集

淋巴细胞

嗜多色性红细胞

网织红细胞

血小板聚集

幼稚红细胞多倍体

中性粒细胞鼓槌体
幼稚单核细胞

脂肪细胞

细胞开会:1.嗜碱性粒细胞,2.中性杆状核粒细胞,3.淋巴细胞,4.中性中幼粒细胞,5.中性分叶核粒细胞,6.单核细胞,7.嗜酸性粒细胞,8.晚幼红细胞
看了这53张图片,你是不是觉得,很多细胞都似曾相识,但就是对不上号。大家只有多看多练习反复强化才能加深印象、强化记忆!
检验视界网微信平台独家首发,转载请注明来源及作者!

